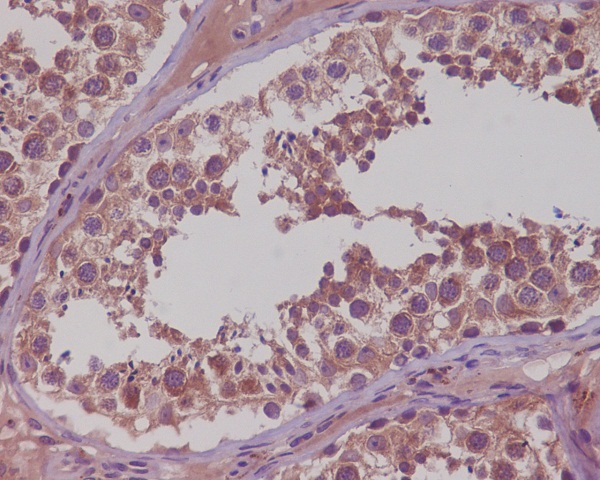
Immunohistochemical analysis of paraffin-embedded human testis, using NAK/TBK1 (N-term) Antibody.

-
Product Name
Anti-TNK1/NAK Rabbit antibody
- Documents
-
Description
TNK1/NAK Rabbit polyclonal antibody
-
Tested applications
WB, IHC-P, ICC/IF
-
Species reactivity
Human, Mouse, Rat
-
Isotype
Rabbit IgG
-
Preparation
Antigen: A synthesized peptide derived from human NAK/TBK1 (N-term)
-
Clonality
Polyclonal
-
Formulation
Rabbit IgG in phosphate buffered saline , pH 7.4, 150mM NaCl, 0.02% sodium azide and 50% glycerol.
-
Storage instructions
Store at 4°C short term. Store at -20°C long term. Avoid freeze / thaw cycle.
-
Applications
WB: 1/500-1/2000
IHC: 1/50-1/200
ICC/IF: 1/50-1/200
-
Validations
Immunohistochemical analysis of paraffin-embedded human testis, using NAK/TBK1 (N-term) Antibody.

Western blot analysis of extracts from MCF7, SKOV-3 and K562 cells using NAK/TBK1 (N-term) Rabbit pAb at 1:1000 dilution. Predicted band size: 84kDa. Observed band size: 84kDa.

Immunofluorescent analysis of MCF7 cells, using NAK/TBK1 (N-term) Antibody.
-
Background
Swiss-Prot Acc.Q9UHD2.The NF-kappa-B (NFKB) complex of proteins is inhibited by I-kappa-B (IKB) proteins, which inactivate NFKB by trapping it in the cytoplasm. Phosphorylation of serine residues on the IKB proteins by IKB kinases marks them for destruction via the ubiquitination pathway, thereby allowing activation and nuclear translocation of the NFKB complex.
Related Products / Services
Please note: All products are "FOR RESEARCH USE ONLY AND ARE NOT INTENDED FOR DIAGNOSTIC OR THERAPEUTIC USE"
